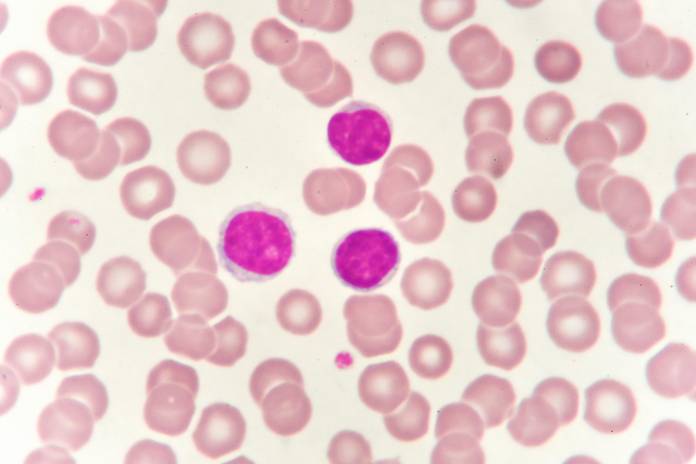

Die weißen Blutkörperchen oder Leukozyten („leukos“ altgriechisch: weiß; „cytos“ altgriechisch: Höhlung) haben spezielle Funktionen in der Abwehr von Krankheitserregern und körperfremden Stoffen. Sie sind damit Teil des Immunsystems. Die Leukozyten werden nach Funktion und Aussehen in drei Untergruppen unterteilt:
Lymphozyten werden im lymphatischen Gewebe (Lymphknoten, Milz und Thymus) oder im Knochenmark gebildet. Nach dem Entstehungsort werden T-Lymphozyten (T für Thymus, Teil des lymphatischen Gewebes) und B-Lymphozyten (B für bone marrow, Knochenmark) unterschieden. Die dritte Gruppe der Lymphozyten sind die natürlichen Killerzellen (NK-Zellen). Sie sind darauf spezialisiert, infizierte Zellen oder Tumorzellen zu erkennen und direkt zu zerstören.
Während andere Leukozyten (wie zum Beispiel die Granulozyten) zum unspezifischen Immunsystem gehören und so Erreger direkt beim Eindringen bekämpfen können, zählen Lymphozyten (außer den NK-Zellen) zum spezifischen Immunsystem. Sie haben Rezeptoren an ihrer Oberfläche, mit denen sie bestimmte Strukturen von Erregern erkennen und diese gezielt angreifen können. Die vollständige Immunantwort benötigt allerdings Stunden bis Tage und tritt erst nach der unspezifischen Reaktion auf.
Lymphozyten sind weiße Blutkörperchen, die wichtige Aufgaben im Immunsystem haben. Zum Beispiel dienen sie der Abwehr von Pilzen, Bakterien, Viren und Parasiten.
Natürliche Killerzellen vernichten infizierte Zellen und Tumorzellen. Sie arbeiten schnell und ungerichtet, sind daher Teil des unspezifischen Immunsystems.
B-Lymphozyten und T-Lymphozyten haben spezielle Rezeptoren auf ihrer Oberflächen damit erkennen sie fremde Strukturen (Antigene) auf Zellen oder Erregern und vernichten sie. Sie sind Teil des spezifischen Immunsystems.
Die Rezeptoren entwickeln sich während der Reifung der Lymphozyten nach dem Zufallsprinzip. Wird einem Lymphozyten sein Antigen präsentiert, vermehrt er sich im lymphatischen Gewebe. So wird eine ganze Armee an Zellen gebildet, die gerichtet gegen den Eindringling vorgehen. Da dies einige Zeit in Anspruch nimmt, kann es ein paar Tage dauern, bis die spezifische Immunabwehr einsetzt. Wenn sie einen Feind einmal erkannt und bekämpft haben, können sie diesen bei erneutem Kontakt sofort identifizieren und schneller angreifen. Sie werden daher auch Gedächtniszellen genannt und sind damit Teil des immunologischen Gedächtnisses.
Man unterscheidet drei Unterarten der Lymphozyten. Natürliche Killerzellen haben die Aufgabe, infizierte Zellen oder Tumorzellen direkt anzugreifen und zu zerstören. Sie sind Teil des unspezifischen Immunsystems.
B-Lymphozyten reifen im Knochenmark (b für bone marrow). Sie produzieren sogenannte Antikörper, also Stoffe die gezielt artfremde Substanzen (Antigene) angreifen. Außerdem unterstützen sie Zellen des unspezifischen Immunsystems bei der Erregerelimination.
T- Lymphozyten reifen im lymphatischen Gewebe (T für Thymus). Sie können Zellen des Immunsystems bei der Bekämpfung von Pathogenen unterstützen (T-Helferzellen). Sobald sie Antigene (körperfremde Eiweißstoffe) auf der Oberfläche von Eindringlingen erkennen, locken sie zum Beispiel B-Lymphozyten an, die mit Ihren Antikörpern den Fremdkörper bekämpfen. Außerdem können sie veränderte (Tumorzellen) bzw. mit Viren infizierte Zellen direkt abtöten (Zytotoxische T-Zellen).
| Lymphozyten | Aufgabe und Funktion |
|---|---|
| B-Lymphozyten | Sind Vorläufer der Plasmazellen. |
| Plasmazellen | Sind Spezialisten für Antikörperproduktion. |
| B-Gedächtniszellen | Langlebige Zellen, speichern Informationen über Eindringlinge und lösen bei einer erneuten Infektion mit dem gleichen Erreger eine schnellere Reaktion aus. |
| T-Helferzellen | Sie aktivieren die Plasmazellen und die Killerzellen und erkennen Antigene (Fremdlinge). |
| Regulatorische T-Zellen | Bremsen die Immunabwehr und dienen der Regulierung. |
| T-Gedächtniszellen | Langlebige T-Zellen mit einem Gedächtnis für Antigene (Fremdlinge) |
| T-Killerzellen | Erkennen Zellen, die von Viren befallen sind und zerstören sie. Sind auch an der Bekämpfung von Tumorzellen beteiligt. |
| Natürliche Killerzellen | Zerstören Zellen, die von Viren befallen sind. Sind auch an der Bekämpfung von Tumorzellen beteiligt. Unspezifische Reaktion. |

Wie alle Leukozyten sind auch Lymphozyten von kugelförmiger Gestalt. Mit einem Durchmesser von 12 μm sind sie die kleinsten Leukozyten. Sie besitzen einen relativ großen Zellkern, der sich mit der sogenannten Pappenheim-Färbung gut anfärben lässt. Bei der Abwehr bestimmter Krankheitserreger kommt es zu Veränderungen ihrer Gestalt. Man spricht auch von atypischen Lymphozyten. Die Größe nimmt zu und der Zellkern verändert sich. Diese Veränderung deutet auf das Vorliegen bestimmter Erkrankungen hin und hilft die Ursache für eine Veränderung der Lymphozytenwerte im Blut zu finden.
Die Blutwerte für Leukozyten werden im kleinen Blutbild ermittelt. Sind die Leukozytenwerte verändert wird ein Differentialblutbild angefertigt. Kleines Blutbild und Differentialblutbild bilden zusammen das große Blutbild. Im Differentialblutbild sind die einzelnen Unterarten im Verhältnis zur Gesamtleukozytenzahl (in Prozent) und ihre Zellzahl pro Mikroliter (µl) Blut angegeben.
In einem Mikroliter Blut findet man 1.500 bis 3.000 Lmyphozyten.
Eine Übersicht über das Differentialblutbild mit allen Normwerten gibt folgende Tabelle:
| Zellen | in Prozent | pro µl Blut | weitere Infos |
|---|---|---|---|
| Alle weißen Blutkörperchen (Leukozyten) | 100% | 4.000-10.000 | Leukozytose (zu hoch) Leukozytopenie (zu niedrig) |
| Neutrophile Granulozyten (segmentkernig) | 50-70% | 3.000-5.800 | Neutrophilie (zu hoch) Neutropenie (zu niedrig) |
| Neutrophile Granulozyten (stabkernig) | 3-5% | 150-400 | |
| Basophile Granulozyten | 0-1% | 15-40 | Basophilie (zu hoch) Basopenie (zu niedrig) |
| Eosinophile Granulozyten | 1-4% | 50-250 | Eosinophilie (zu hoch) Eosinopenie (zu niedrig) |
| Monozyten | 3-7% | 285-500 | Monozytose (zu hoch) Monozytopenie (zu niedrig) |
| Lymphozyten | 25-45% | 1.500-3.000 | Lymphozytose (zu hoch) Lymphozytopenie (zu niedrig) |
Innerhalb der Lymphozyten überwiegen die T-Lymphozyten deutlich mit einem Anteil von bis zu 85 Prozent.
Einen Vergleich der Werte für B- und T-Lymphozyten zeigt folgende Tabelle:
| Immunzelle | pro Mikroliter Blut | in Prozent |
|---|---|---|
| T-Lymphozyten | 600 bis 3.000 | 61-85 % |
| B-Lymphozyten | 70 bis 830 | 7-23 % |
Wird bei einer Blutuntersuchung ein erhöhter Wert der weißen Blutkörperchen festgestellt, folgt in der Regel die Anfertigung eines Differentialblutbildes, um zu sehen, welche Zellen für die Erhöhung verantwortlich sind.
Sind die Lymphozyten erhöht, spricht man von einer Lymphozytose.
Der größte Teil der Lymphozyten befindet sich bei Erwachsenen nicht in der Blutbahn, sondern in Knochenmark oder lymphatischen Organen (Thymus, Milz, Lymphknoten, Peyersche-Plaques des Dünndarms). Kommt es zu einer Infektion oder Entzündung, steigen die Werte der Lymphozyten im Blut. Die häufigste Ursache für eine Erhöhung der Lymphozyten im Blut sind Virusinfektionen (wie zum Beispiel das Pfeiffersche Drüsenfieber). Auch bakterielle Infektionen (zum Beispiel die Tuberkulose), einige Krebsarten (Lymphom, Leukämie), Schilddrüsenüberfunktion oder chronische Darmentzündungen (Morbus Crohn) können für einen Anstieg der Lymphozyten verantwortlich sein. Auftretende Symptome sind durch die Erkrankung selber, nicht durch die erhöhten Lymphozytenwerte verursacht. Bei Leukämie oder Lymphomen leiden Betroffene häufig unter Nachtschweiß und Fieber. Beim Pfeifferschen Drüsenfieber kommt es zu geschwollen Lymphknoten und Fieber.
Sind die Lymphozyten erniedrigt spricht man von einer Lymphopenie. Hier unterscheidet man die akute von der chronischen Lymphopenie.
Eine akute Lymphopenie tritt als Folge bestimmter Erkrankungen oder Umstände auf und verschwindet mit der Ursache in der Regel wieder. Hierzu zählen beispielsweise Viruserkrankungen (Hepatits, Grippe), Fasten, Untergewicht, starke körperliche Belastung, die Einnahme bestimmter Medikamente (zum Beispiel Cortison) oder Krebstherapie (Chemotherapie, Bestrahlung).
Chronische Lymphopenien treten im Rahmen langwieriger Erkrankungen und über einen längeren Zeitraum auf. Ursache hierfür können bestimmte Autoimmunerkrankungen (Lupus erythematodes (Kollagenosen), rheumatoide Arthritis, Myasthenia gravis), chronische Erkrankungen (HIV, Tuberkulose) oder einige Krebsarten (Leukämie, Lymphome) sein. Außerdem gibt es vererbbare Immundefekte, die zu dauerhaft erniedrigten Lymphozyten führen.
Bei einer leichten Lymphopenie treten häufig keine Symptome auf. Meistens überwiegen die Symptome der Erkrankung, die die Lymphopenie verursacht haben. Bei Infektionen der Atemwege kommt es zu laufender Nase oder Fieber. Vergrößerte Lymphknoten und Milz können Hinweise auf eine HIV-Erkrankung oder bestimmte Krebsarten geben. Bei einer rheumatoiden Arthritis leiden Betroffene unter starken Gelenkschmerzen. Sehr kleine Lymphknoten können bei erblichen Erkrankungen vorkommen.
Im Patientengespräch wird der Arzt zunächst anhand der Beschwerden eine Verdachtsdiagnose stellen und beispielsweise bei Verdacht auf Infektionserkrankungen ein Blutbild anfertigen lassen. Sind die Leukozyten verändert wird im Differentialblutbild genauer untersucht, welche Leukozytenart für die Veränderung verantwortlich ist.
Beim Vorliegen eine Lymphozytose wird das Blut unter dem Mikroskop betrachtet, um Hinweise auf die Ursache zu bekommen. Durch die aktive Erregerbekämpfung verändern Lymphozyten ihre typische Gestalt. Bei Viruserkrankungen sind die Lymphozyten durch den Virus aktiviert. Unreife oder veränderte Lymphozyten kommen bei Leukämie oder Lymphomen vor. Außerdem kann unter dem Mikroskop erkannt werden, ob es sich um T-Lymphozyten, B-Lymphozyten oder NK-Zellen handelt, was hilfreich sein kann, um die Ursache zu finden. Die Therapie richtet sich nach der Grunderkrankung.
Eine leichte Lymphopenie wird meist nur zufällig im Blutbild entdeckt. Bei immer wiederkehrenden oder sehr schweren Infektionserkrankungen wird gezielt ein großes Blutbild angefertigt. Sind die Lymphozyten stark erniedrigt, folgen weitere Blutuntersuchungen, um den Erreger zu identifizieren (zum Beispiel HIV). Bei Verdacht auf eine Krebserkrankung oder eine bestimmte Infektion werden eine Knochenmarkspunktion und die Untersuchung des Knochenmarks folgen. Eine Behandlung der auslösenden Ursache (sofern möglich) bringt eine Normalisierung der Lymphozytenwerte mit sich. Infektionen werden je nach Erreger gezielt mit Antibiotika, Virustatika oder Antiparasitika behandelt. Patienten mit Immundefekten profitieren von Stammzell- oder Knochenmarkstransplantationen. Da die Infektanfälligkeit durch den Mangel an Lymphozyten deutlich erhöht sein kann (vor allem bei chronischen Erkrankungen wie HIV) werden teilweise Gammaglobuline verabreicht. Diese beinhalten zahlreiche Antikörper, dies beugt Infektionen vor.
aktualisiert am 02.03.2022